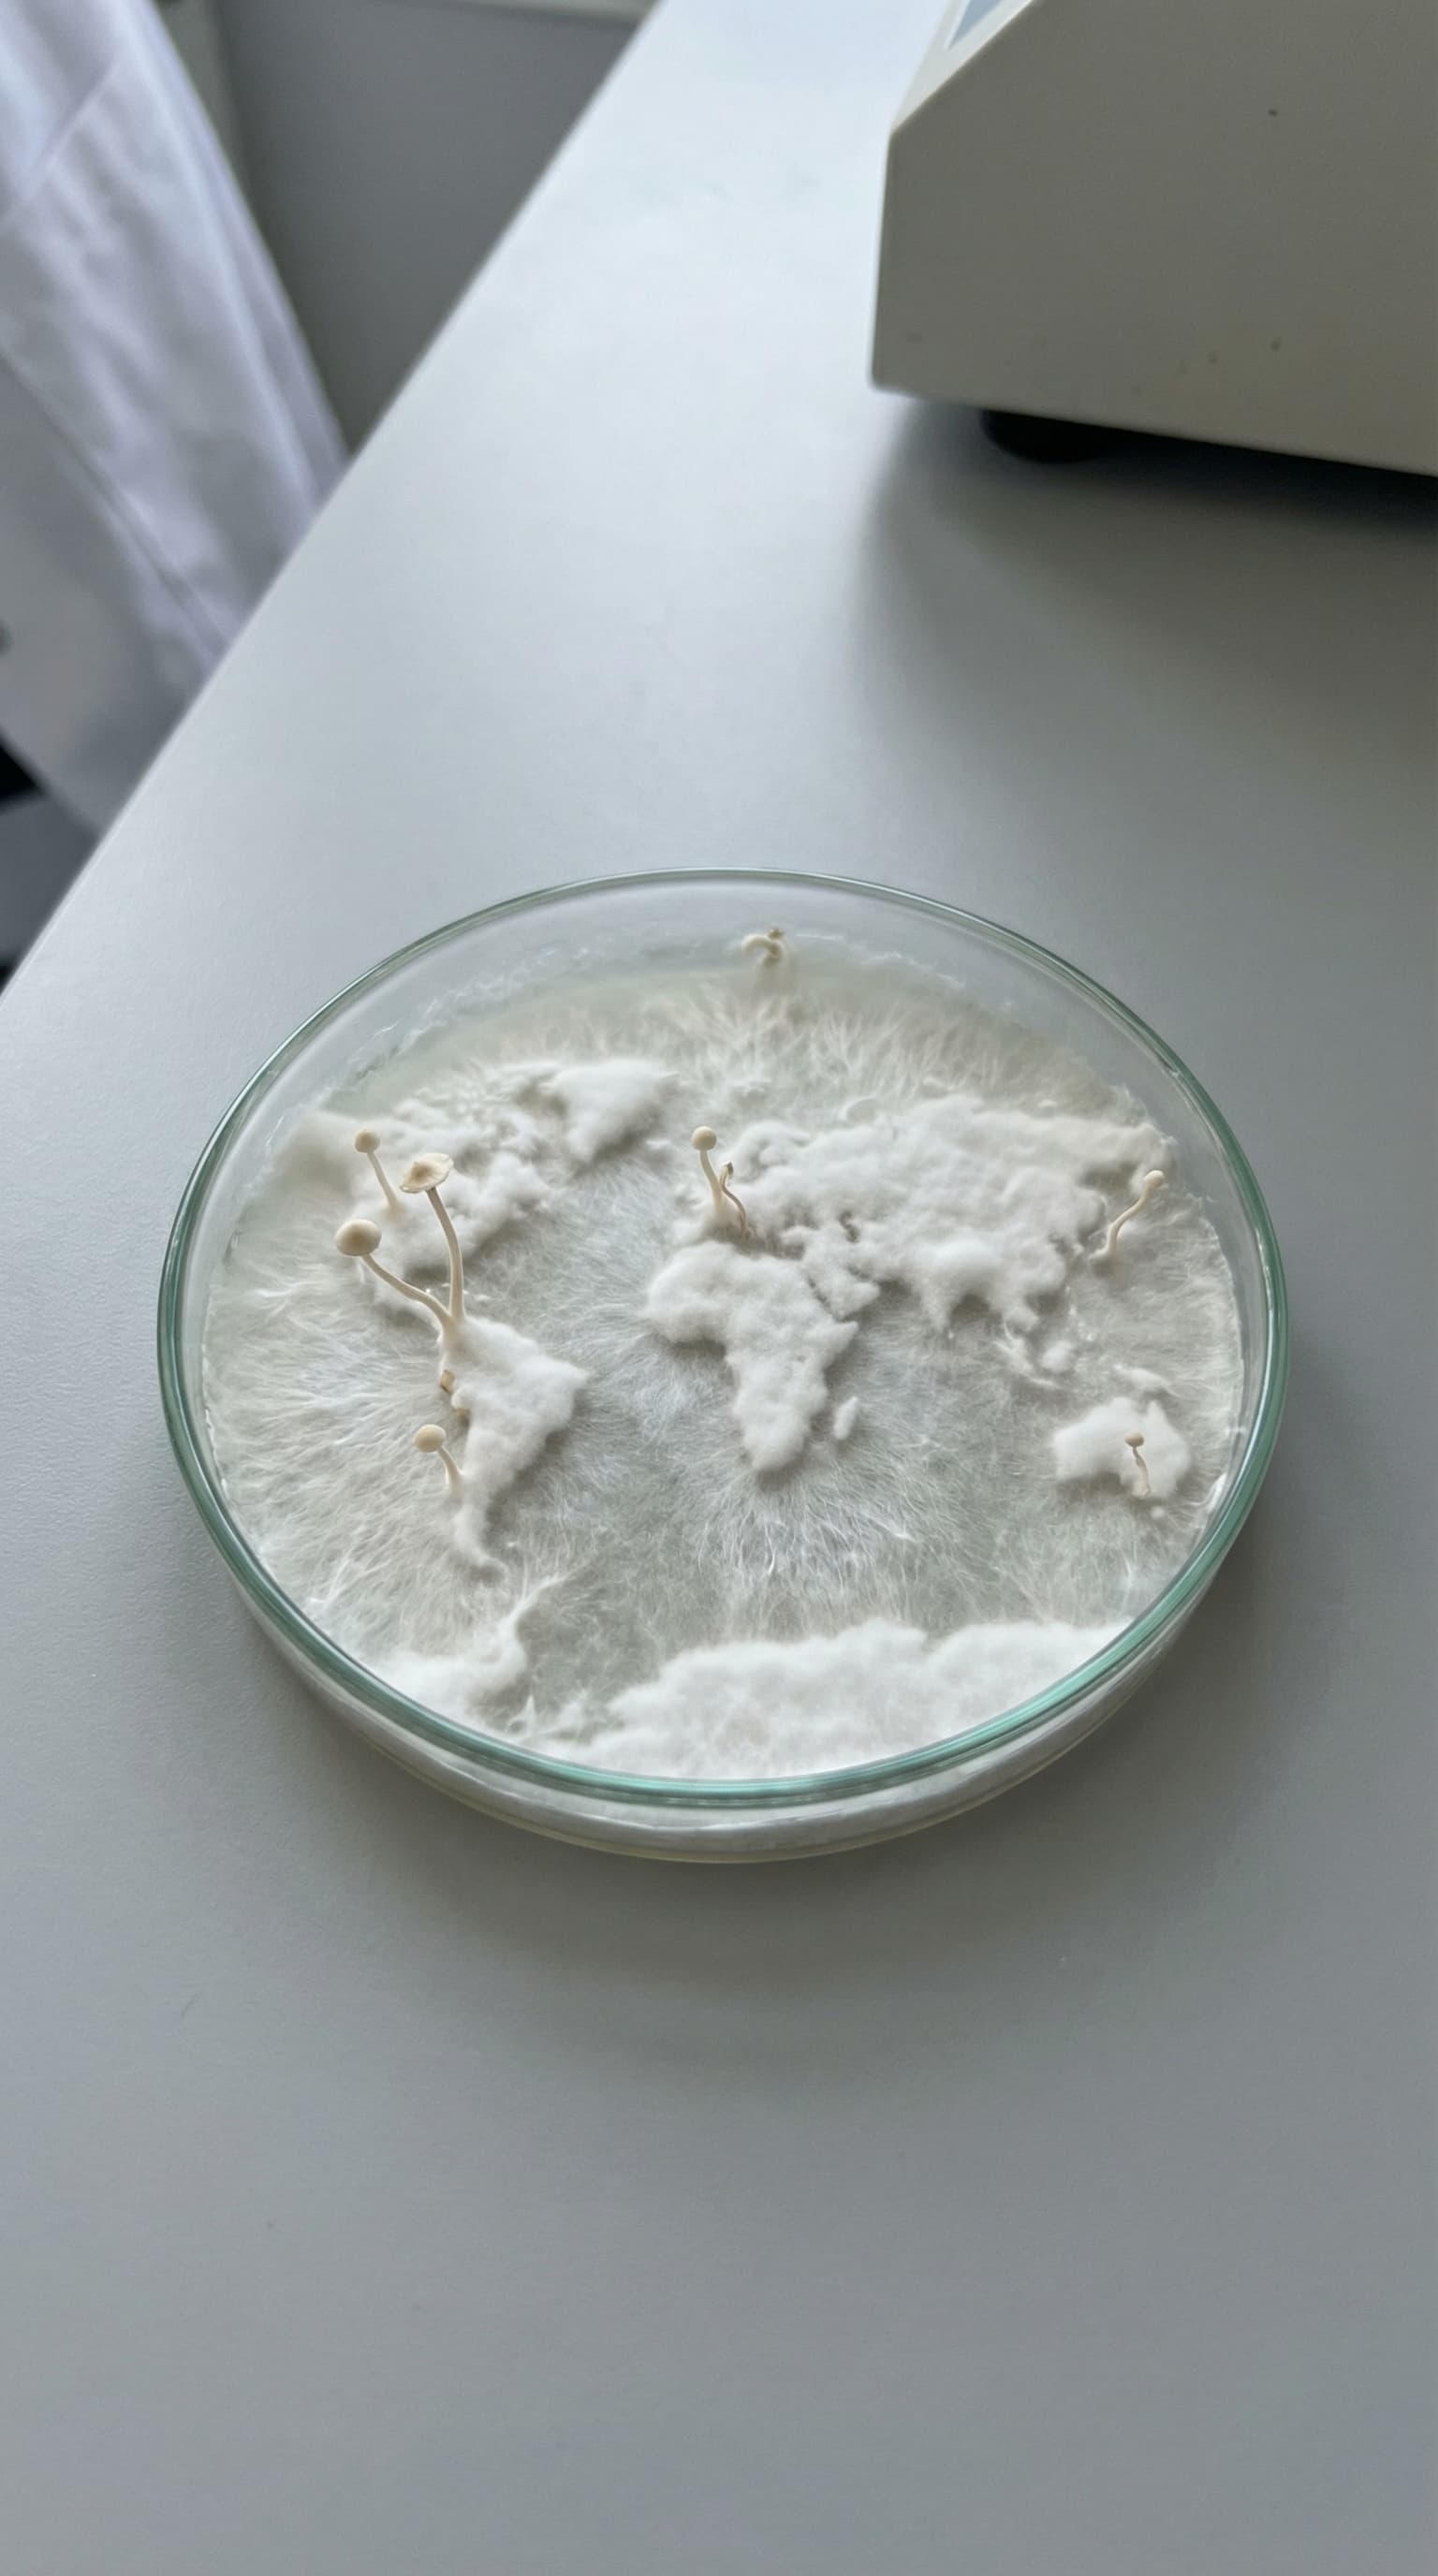
Mycelium dyrket i petriskål under kontrollerede laboratorieforhold, som illustrerer svampens vækststruktur og udvikling i et defineret kulturmiljø.

NEXT-GEN QUALITY
MUUZ LAB
MUUZ LAB er vores kvalitetsplatform.
Her samler vi det, der normalt ikke forklares.
Oprindelse. Dyrkning. Ekstraktion.
Koncentration. Testning. Kvalitetssikring.
Ikke som marketing.
Men som dokumentation.
90%
af de brands vi har gennemgået deler ikke deres COA-rapporter offentligt.
Se COA rapporter →Kvalitet er ikke tilfældig.
Kvalitet er et system.
Funktionelle svampe er komplekse råvarer.
Deres kvalitet afhænger af mere end navnet på etiketten.
– Hvor de dyrkes
– Hvordan de dyrkes
– Hvilken del af svampen der anvendes til ekstraktet
– Hvordan bioaktive metabolitter udvindes
– Hvordan ekstraktet standardiseres
– Hvordan hver batch dokumenteres
Hos MUUZ arbejder vi systematisk med hvert led.
MUUZ LAB gør processen synlig.
Transparens som standard.

Hvorfor funktionelle svampe skal forarbejdes
De bioaktive forbindelser i funktionelle svampe findes inde i svampens celler.
Disse celler er omgivet af chitin (kitin)-cellevægge — et stærkt, strukturelt materiale, som menneskets fordøjelsessystem ikke selv kan nedbryde effektivt. I modsætning til mange planteceller er svampens cellevæg særligt modstandsdygtig.
Denne struktur er afgørende for svampens overlevelse i naturen. Den beskytter mod miljøpåvirkninger og nedbrydning. Men den samme struktur fungerer som en barriere, når svampen indtages uforarbejdet.
For at de bioaktive forbindelser kan blive tilgængelige, skal cellevæggene åbnes, og forbindelserne frigives. Det kræver kontrolleret forarbejdning, hvor faktorer som temperatur, tid og ekstraktionsmetode spiller en afgørende rolle.
Uden denne proces forbliver mange af svampens centrale forbindelser fysisk utilgængelige for kroppen — uanset svampens oprindelse eller råvarekvalitet.
Det betyder, at kvalitet i funktionelle svampe ikke alene handler om hvad der dyrkes, men også hvordan det forarbejdes.
Uden korrekt forarbejdning vil store dele af råmaterialet derfor passere gennem kroppen uden at blive udnyttet.
→ Derfor er ekstraktion ikke et valg.
→ Det er en forudsætning.

Ekstraktion
Ekstraktion er en kontrolleret proces, hvor et råmateriale udsættes for et opløsningsmiddel – typisk vand, ethanol eller en kombination – for at frigive de bioaktive forbindelser, som kendetegner funktionelle svampe.
Efter ekstraktionen fjernes opløsningsmidlet helt eller delvist, og ekstraktet kan foreligge i forskellige formater:
– tørret til pulver
– eller i flydende form, med eller uden opløsningsmiddel i slutproduktet (fx flydende ekstrakter eller tinkturer)
Valget af format har betydning for koncentration, stabilitet og mulighed for standardisering – og spiller derfor en central rolle i kvaliteten af det færdige produkt.
MUUZ arbejder udelukkende med tørrede pulverekstrakter, da formatet muliggør en højere koncentration og et mere kontrolleret udbytte af svampenes bioaktive forbindelser.

Vand, ethanol og hvad forskningen viser
Forskning inden for funktionelle svampe viser, at de centrale bioaktive forbindelser i svampe – herunder polysakkarider og beta-glucaner – primært er vandopløselige.
Disse forbindelser opløses effektivt i vand, mens opløseligheden i ethanol er meget begrænset. Studier dokumenterer, at når ethanol er til stede i det færdige ekstrakt – selv ved koncentrationer omkring 20 % – reduceres udbyttet af polysakkarider og beta-glucaner til niveauer, der ofte er meget lave eller vanskelige at måle analytisk.
Af den grund anvendes ethanol i moderne svampeekstraktion ikke som primært opløsningsmiddel til udvinding af vandopløselige forbindelser, men som et sekundært teknisk trin i processen.
Vand udgør grundlaget for udvindingen.
Alkohol anvendes, når processen kræver det.

Slutprodukt, ethanol og format
Når man vurderer funktionelle svampeprodukter, er formatet mindre afgørende end slutproduktets sammensætning.
Det centrale skel går mellem produkter, hvor ethanol er til stede i slutproduktet, og produkter hvor det ikke er.
Polysakkarider og beta-glucaner er vandopløselige forbindelser. Når ethanol er til stede i det færdige produkt – selv i moderate koncentrationer – påvirkes sammensætningen af disse forbindelser.
Flydende tinkturer og visse flydende ekstrakter indeholder ethanol i slutproduktet, typisk af stabilitets- og holdbarhedshensyn. Tilstedeværelsen af ethanol påvirker samtidig sammensætningen af vandopløselige svampefraktioner.
I moderne ekstraktionsprocesser kan ethanol anvendes som et midlertidigt procesmiddel, som fjernes fuldstændigt før tørring eller videreforarbejdning.
Kvalitet handler derfor ikke om, hvorvidt et produkt er flydende eller i pulverform – men om hvilke forbindelser der er bevaret i det færdige produkt.

Enkelt- og dobbelt-ekstraktion
Ikke alle funktionelle svampe har samme kemiske sammensætning.
Derfor kræver de heller ikke nødvendigvis samme ekstraktionsproces.
Nogle bioaktive forbindelser er primært vandopløselige, mens andre er mere opløselige i alkoholbaserede opløsningsmidler.
Ved enkelt-ekstraktion anvendes én metode, typisk varmt vand, når dette er tilstrækkeligt til at udvinde de relevante forbindelser fra svampen.
Ved dobbelt-ekstraktion kombineres to separate trin, hvor vand- og alkoholekstraktion udføres hver for sig. Opløsningsmidlerne fjernes efterfølgende fuldstændigt, før ekstraktet tørres.
Valget mellem enkelt- og dobbelt-ekstraktion afhænger ikke kun af opløsningsmiddel, men også af procesparametre som temperatur, tid og kontrol. Den samme metode kan derfor give forskellige resultater, afhængigt af hvordan den udføres.
Dobbelt-ekstraktion anvendes kun, når det giver mening i forhold til de specifikke bioaktive forbindelser, der ønskes udvundet.
Ekstraktionsmetoden bør derfor vælges ud fra svampens sammensætning — ikke som en standardløsning.

Oprindelse og dyrkning
Kvaliteten af funktionelle svampe begynder før ekstraktion.
Den afgøres af, hvor svampen dyrkes, hvordan den dyrkes, og hvilket biologisk materiale der anvendes.
MUUZ arbejder med dokumenterede råvarer fra udvalgte regioner, hvor svampedyrkning har århundredlange traditioner og mulighed for reel kvalitetskontrol. At vores svampe stammer fra Kina er ikke et spørgsmål om pris, men om klima, erfaring og specialisering. Kina er fortsat det globale centrum for svampedyrkning, netop fordi disse regioner har produceret, dyrket og forarbejdet svampe i generationer.
Oprindelse
Reishi: Zhejiang- og Gutian-regionerne, Kina
Lion’s Mane: Fujian-provinsen, Kina
Chaga: Heilongjiang- og Jilin-regionerne, Kina samt udvalgte estiske skove
Cordyceps: Fujian-provinsen, Kina
Disse områder er valgt for deres klima, erfaring og sporbarhed — ikke fordi de er billige.
Dyrkning og forarbejdning
Vores partnere arbejder med naturlige, ikke-syntetiske substrater, rent vand og kontrollerede vækstmiljøer. Svampene dyrkes i åbne eller semi-åbne drivhuse og tørres skånsomt via soltørring eller lav-temperatur dehydrering for at bevare deres naturlige struktur.
Efter høst gennemgår råmaterialet en indledende kvalitetskontrol, før det anvendes til ekstraktion. Her testes blandt andet for mikrobiologisk sikkerhed (fx gær, skimmel, Salmonella og E. coli), uønskede stoffer som tungmetaller, pesticider og restopløsningsmidler samt tilstedeværelse af strukturelle svampekomponenter som beta-glucaner. Kun råmateriale, der opfylder disse grundlæggende kvalitetskrav, går videre i processen.
Substrater og biologisk materiale
Reishi dyrkes på hårdttræ.
Lion’s Mane dyrkes på organiske plantebaserede vækstmedier.
Chaga høstes vildt fra birketræer.
Cordyceps fremstilles via kontrolleret fermentering for stabil og reproducerbar kvalitet.
Økologisk certificering
Langt størstedelen af MUUZ’ råvarer er certificeret økologiske. Certificeringen indgår som en del af et bredere kvalitetssystem, hvor dokumentation, sporbarhed og analyse er afgørende — ikke et mål i sig selv.

Hvorfor test er nødvendigt
Markedet for funktionelle svampe er vokset hurtigt. Samtidig er de metoder, der ofte bruges til at vurdere kvalitet, ikke fulgt med i samme tempo.
Tal som ekstraktionsratioer eller angivet antal mg pr. kapsel kan give et overordnet indtryk, men siger i sig selv meget lidt om, hvad et ekstrakt faktisk indeholder — og i hvilken kvalitet.
Funktionelle svampe er biologisk aktive organismer. Under vækst interagerer de direkte med deres omgivelser og optager stoffer fra substrat, træ, jord og vand. Det gælder både ønskede bioaktive forbindelser og uønskede stoffer fra miljøet.
Af den grund er analytisk test en forudsætning for kvalitet — ikke et ekstra tilvalg.
Hos MUUZ testes råmaterialer og ekstrakter blandt andet for:
– mikrobiologisk sikkerhed
– tungmetaller, pesticider og restopløsningsmidler
– strukturelle svampekomponenter som beta-glucaner
Uden systematisk test kan et produkt fremstå korrekt på etiketten og stadig mangle de forbindelser, der gør funktionelle svampe funktionelle.
Test er derfor ikke kun et spørgsmål om sikkerhed.
Det er den eneste måde at verificere indhold, renhed og reel kvalitet på.

Hvad måler vi,og hvorfor
Beta-glucaner anvendes ofte som en grundlæggende kvalitetsmarkør for funktionelle svampe. De er en naturlig del af svampens cellevæg og fungerer som en indikator for, at et ekstrakt faktisk indeholder svampemateriale — og ikke primært fyldstoffer som korn, stivelse eller restbiomasse.
Beta-glucaner er derfor vigtige som baseline for kvalitet.
Samtidig er det vigtigt at forstå, at beta-glucaner ikke står alene. De er en del af den samlede gruppe af polysakkarider i svampen og skal ikke læses som et separat eller additivt tal.
Funktionelle svampe indeholder en bred vifte af bioaktive forbindelser — både store strukturelle molekyler og mindre metabolitter — som tilsammen udgør svampens kemiske profil. Et ekstrakt kan derfor godt opfylde én kvalitetsmarkør og stadig mangle andre forbindelser, der naturligt hører til svampen.
Derfor tester MUUZ ikke kun for beta-glucaner og polysakkarider, men vurderer sammensætningen som helhed. Afhængigt af svampetype kan analyser blandt andet omfatte:
– nukleosider
– steroler og triterpener
– svovlholdige og antioxidative forbindelser
– arts-specifikke markørstoffer
Disse forbindelser forekommer i meget forskellige koncentrationer og kan ikke vurderes ud fra ekstraktionsratioer eller ét enkelt tal alene.
Af den grund er en fyldestgørende, batch-specifik Certificate of Analysis (COA) afgørende. Tallene dokumenterer, hvad et ekstrakt faktisk indeholder — og hvad det ikke indeholder. De kan ikke fortolkes væk, og de kan ikke pyntes på.
MUUZ er ikke bange for at vise tallene.
For i sidste ende er det dokumentationen, der afgør, om et produkt er et kvalitetsprodukt.

Målt. Testet. Dokumenteret
Når kvalitet skal vurderes objektivt, er dokumentation afgørende.
Ikke generelle specifikationer, men analyser foretaget på den konkrete batch, der ender i produktet.
Derfor arbejder MUUZ med batch-specifik testning.
Hver produktion analyseres uafhængigt hos Purity-IQ, og resultaterne samles i en Certificate of Analysis (COA).
En COA er ikke et markedsføringsdokument, men en laboratorierapport, der viser, hvad et ekstrakt faktisk indeholder — baseret på målte data.
Hver eneste batch, der produceres til MUUZ, testes før frigivelse.
Først når analyserne bekræfter identitet, renhed og indhold, godkendes batchen til salg.
Hvis en batch ikke lever op til vores standarder, bliver den ikke et MUUZ-produkt.
Afhængigt af svampetype og ekstrakt anvendes forskellige analytiske metoder, fordi ikke alle bioaktive forbindelser kan måles på samme måde.
Metoderne vælges ud fra, hvad der analyseres — ikke ud fra, hvad der er lettest at vise.
MUUZ anvender blandt andet:
– enzymatiske analyser til kvantificering af beta-glucaner
– kromatografiske metoder (fx LC-MS) til identifikation og måling af specifikke bioaktive forbindelser
– NMR-analyse til molekylær profilering og bekræftelse af ekstraktets identitet
– ICP-analyse til tungmetaller
– mikrobiologiske tests for gær, skimmel og patogener
Disse analyser gør det muligt at vurdere både sikkerhed, renhed og indhold — og at skelne mellem reelle svampeekstrakter og produkter, der primært består af restbiomasse eller fyld.
En fyldestgørende COA dokumenterer blandt andet:
– identitet og sporbarhed
– fravær af uønskede stoffer
– indhold af relevante strukturelle og bioaktive forbindelser
COA’en er direkte knyttet til batchnummeret og gøres tilgængelig via QR-kode på hvert produkt.
Det betyder, at dokumentationen altid vedrører præcis den batch, du køber — ikke et gennemsnit, en standard eller historiske tal.
Tallene i en COA kan ikke fortolkes frit.
De viser, hvad der er til stede — og hvad der ikke er.
MUUZ er ikke bange for at vise tallene.
For når kvalitet er reel, tåler den at blive målt.
Hvorfor funktionelle svampe skal forarbejdes
De bioaktive forbindelser i funktionelle svampe findes inde i svampens celler.
Disse celler er omgivet af chitin (kitin)-cellevægge — et stærkt, strukturelt materiale, som menneskets fordøjelsessystem ikke selv kan nedbryde effektivt. I modsætning til mange planteceller er svampens cellevæg særligt modstandsdygtig.
Denne struktur er afgørende for svampens overlevelse i naturen. Den beskytter mod miljøpåvirkninger og nedbrydning. Men den samme struktur fungerer som en barriere, når svampen indtages uforarbejdet.
For at de bioaktive forbindelser kan blive tilgængelige, skal cellevæggene åbnes, og forbindelserne frigives. Det kræver kontrolleret forarbejdning, hvor faktorer som temperatur, tid og ekstraktionsmetode spiller en afgørende rolle.
Uden denne proces forbliver mange af svampens centrale forbindelser fysisk utilgængelige for kroppen — uanset svampens oprindelse eller råvarekvalitet.
Det betyder, at kvalitet i funktionelle svampe ikke alene handler om hvad der dyrkes, men også hvordan det forarbejdes.
Uden korrekt forarbejdning vil store dele af råmaterialet derfor passere gennem kroppen uden at blive udnyttet.
→ Derfor er ekstraktion ikke et valg.
→ Det er en forudsætning.
Ekstraktion
Ekstraktion er en kontrolleret proces, hvor et råmateriale udsættes for et opløsningsmiddel – typisk vand, ethanol eller en kombination – for at frigive de bioaktive forbindelser, som kendetegner funktionelle svampe.
Efter ekstraktionen fjernes opløsningsmidlet helt eller delvist, og ekstraktet kan foreligge i forskellige formater:
– tørret til pulver
– eller i flydende form, med eller uden opløsningsmiddel i slutproduktet (fx flydende ekstrakter eller tinkturer)
Valget af format har betydning for koncentration, stabilitet og mulighed for standardisering – og spiller derfor en central rolle i kvaliteten af det færdige produkt.
MUUZ arbejder udelukkende med tørrede pulverekstrakter, da formatet muliggør en højere koncentration og et mere kontrolleret udbytte af svampenes bioaktive forbindelser.
Vand, ethanol og hvad forskningen viser
Forskning inden for funktionelle svampe viser, at de centrale bioaktive forbindelser i svampe – herunder polysakkarider og beta-glucaner – primært er vandopløselige.
Disse forbindelser opløses effektivt i vand, mens opløseligheden i ethanol er meget begrænset. Studier dokumenterer, at når ethanol er til stede i det færdige ekstrakt – selv ved koncentrationer omkring 20 % – reduceres udbyttet af polysakkarider og beta-glucaner til niveauer, der ofte er meget lave eller vanskelige at måle analytisk.
Af den grund anvendes ethanol i moderne svampeekstraktion ikke som primært opløsningsmiddel til udvinding af vandopløselige forbindelser, men som et sekundært teknisk trin i processen.
Vand udgør grundlaget for udvindingen.
Alkohol anvendes, når processen kræver det.
Slutprodukt, ethanol og format
Når man vurderer funktionelle svampeprodukter, er formatet mindre afgørende end slutproduktets sammensætning.
Det centrale skel går mellem produkter, hvor ethanol er til stede i slutproduktet, og produkter hvor det ikke er.
Polysakkarider og beta-glucaner er vandopløselige forbindelser. Når ethanol er til stede i det færdige produkt – selv i moderate koncentrationer – påvirkes sammensætningen af disse forbindelser.
Flydende tinkturer og visse flydende ekstrakter indeholder ethanol i slutproduktet, typisk af stabilitets- og holdbarhedshensyn. Tilstedeværelsen af ethanol påvirker samtidig sammensætningen af vandopløselige svampefraktioner.
I moderne ekstraktionsprocesser kan ethanol anvendes som et midlertidigt procesmiddel, som fjernes fuldstændigt før tørring eller videreforarbejdning.
Kvalitet handler derfor ikke om, hvorvidt et produkt er flydende eller i pulverform – men om hvilke forbindelser der er bevaret i det færdige produkt.
Enkelt- og dobbelt-ekstraktion
Ikke alle funktionelle svampe har samme kemiske sammensætning.
Derfor kræver de heller ikke nødvendigvis samme ekstraktionsproces.
Nogle bioaktive forbindelser er primært vandopløselige, mens andre er mere opløselige i alkoholbaserede opløsningsmidler.
Ved enkelt-ekstraktion anvendes én metode, typisk varmt vand, når dette er tilstrækkeligt til at udvinde de relevante forbindelser fra svampen.
Ved dobbelt-ekstraktion kombineres to separate trin, hvor vand- og alkoholekstraktion udføres hver for sig. Opløsningsmidlerne fjernes efterfølgende fuldstændigt, før ekstraktet tørres.
Valget mellem enkelt- og dobbelt-ekstraktion afhænger ikke kun af opløsningsmiddel, men også af procesparametre som temperatur, tid og kontrol. Den samme metode kan derfor give forskellige resultater, afhængigt af hvordan den udføres.
Dobbelt-ekstraktion anvendes kun, når det giver mening i forhold til de specifikke bioaktive forbindelser, der ønskes udvundet.
Ekstraktionsmetoden bør derfor vælges ud fra svampens sammensætning — ikke som en standardløsning.
Oprindelse og dyrkning
Kvaliteten af funktionelle svampe begynder før ekstraktion.
Den afgøres af, hvor svampen dyrkes, hvordan den dyrkes, og hvilket biologisk materiale der anvendes.
MUUZ arbejder med dokumenterede råvarer fra udvalgte regioner, hvor svampedyrkning har århundredlange traditioner og mulighed for reel kvalitetskontrol. At vores svampe stammer fra Kina er ikke et spørgsmål om pris, men om klima, erfaring og specialisering. Kina er fortsat det globale centrum for svampedyrkning, netop fordi disse regioner har produceret, dyrket og forarbejdet svampe i generationer.
Oprindelse
Reishi: Zhejiang- og Gutian-regionerne, Kina
Lion’s Mane: Fujian-provinsen, Kina
Chaga: Heilongjiang- og Jilin-regionerne, Kina samt udvalgte estiske skove
Cordyceps: Fujian-provinsen, Kina
Disse områder er valgt for deres klima, erfaring og sporbarhed — ikke fordi de er billige.
Dyrkning og forarbejdning
Vores partnere arbejder med naturlige, ikke-syntetiske substrater, rent vand og kontrollerede vækstmiljøer. Svampene dyrkes i åbne eller semi-åbne drivhuse og tørres skånsomt via soltørring eller lav-temperatur dehydrering for at bevare deres naturlige struktur.
Efter høst gennemgår råmaterialet en indledende kvalitetskontrol, før det anvendes til ekstraktion. Her testes blandt andet for mikrobiologisk sikkerhed (fx gær, skimmel, Salmonella og E. coli), uønskede stoffer som tungmetaller, pesticider og restopløsningsmidler samt tilstedeværelse af strukturelle svampekomponenter som beta-glucaner. Kun råmateriale, der opfylder disse grundlæggende kvalitetskrav, går videre i processen.
Substrater og biologisk materiale
Reishi dyrkes på hårdttræ.
Lion’s Mane dyrkes på organiske plantebaserede vækstmedier.
Chaga høstes vildt fra birketræer.
Cordyceps fremstilles via kontrolleret fermentering for stabil og reproducerbar kvalitet.
Økologisk certificering
Langt størstedelen af MUUZ’ råvarer er certificeret økologiske. Certificeringen indgår som en del af et bredere kvalitetssystem, hvor dokumentation, sporbarhed og analyse er afgørende — ikke et mål i sig selv.
Hvorfor test er nødvendigt
Markedet for funktionelle svampe er vokset hurtigt. Samtidig er de metoder, der ofte bruges til at vurdere kvalitet, ikke fulgt med i samme tempo.
Tal som ekstraktionsratioer eller angivet antal mg pr. kapsel kan give et overordnet indtryk, men siger i sig selv meget lidt om, hvad et ekstrakt faktisk indeholder — og i hvilken kvalitet.
Funktionelle svampe er biologisk aktive organismer. Under vækst interagerer de direkte med deres omgivelser og optager stoffer fra substrat, træ, jord og vand. Det gælder både ønskede bioaktive forbindelser og uønskede stoffer fra miljøet.
Af den grund er analytisk test en forudsætning for kvalitet — ikke et ekstra tilvalg.
Hos MUUZ testes råmaterialer og ekstrakter blandt andet for:
– mikrobiologisk sikkerhed
– tungmetaller, pesticider og restopløsningsmidler
– strukturelle svampekomponenter som beta-glucaner
Uden systematisk test kan et produkt fremstå korrekt på etiketten og stadig mangle de forbindelser, der gør funktionelle svampe funktionelle.
Test er derfor ikke kun et spørgsmål om sikkerhed.
Det er den eneste måde at verificere indhold, renhed og reel kvalitet på.
Hvad måler vi,og hvorfor
Beta-glucaner anvendes ofte som en grundlæggende kvalitetsmarkør for funktionelle svampe. De er en naturlig del af svampens cellevæg og fungerer som en indikator for, at et ekstrakt faktisk indeholder svampemateriale — og ikke primært fyldstoffer som korn, stivelse eller restbiomasse.
Beta-glucaner er derfor vigtige som baseline for kvalitet.
Samtidig er det vigtigt at forstå, at beta-glucaner ikke står alene. De er en del af den samlede gruppe af polysakkarider i svampen og skal ikke læses som et separat eller additivt tal.
Funktionelle svampe indeholder en bred vifte af bioaktive forbindelser — både store strukturelle molekyler og mindre metabolitter — som tilsammen udgør svampens kemiske profil. Et ekstrakt kan derfor godt opfylde én kvalitetsmarkør og stadig mangle andre forbindelser, der naturligt hører til svampen.
Derfor tester MUUZ ikke kun for beta-glucaner og polysakkarider, men vurderer sammensætningen som helhed. Afhængigt af svampetype kan analyser blandt andet omfatte:
– nukleosider
– steroler og triterpener
– svovlholdige og antioxidative forbindelser
– arts-specifikke markørstoffer
Disse forbindelser forekommer i meget forskellige koncentrationer og kan ikke vurderes ud fra ekstraktionsratioer eller ét enkelt tal alene.
Af den grund er en fyldestgørende, batch-specifik Certificate of Analysis (COA) afgørende. Tallene dokumenterer, hvad et ekstrakt faktisk indeholder — og hvad det ikke indeholder. De kan ikke fortolkes væk, og de kan ikke pyntes på.
MUUZ er ikke bange for at vise tallene.
For i sidste ende er det dokumentationen, der afgør, om et produkt er et kvalitetsprodukt.
Målt. Testet. Dokumenteret
Når kvalitet skal vurderes objektivt, er dokumentation afgørende.
Ikke generelle specifikationer, men analyser foretaget på den konkrete batch, der ender i produktet.
Derfor arbejder MUUZ med batch-specifik testning.
Hver produktion analyseres uafhængigt hos Purity-IQ, og resultaterne samles i en Certificate of Analysis (COA).
En COA er ikke et markedsføringsdokument, men en laboratorierapport, der viser, hvad et ekstrakt faktisk indeholder — baseret på målte data.
Hver eneste batch, der produceres til MUUZ, testes før frigivelse.
Først når analyserne bekræfter identitet, renhed og indhold, godkendes batchen til salg.
Hvis en batch ikke lever op til vores standarder, bliver den ikke et MUUZ-produkt.
Afhængigt af svampetype og ekstrakt anvendes forskellige analytiske metoder, fordi ikke alle bioaktive forbindelser kan måles på samme måde.
Metoderne vælges ud fra, hvad der analyseres — ikke ud fra, hvad der er lettest at vise.
MUUZ anvender blandt andet:
– enzymatiske analyser til kvantificering af beta-glucaner
– kromatografiske metoder (fx LC-MS) til identifikation og måling af specifikke bioaktive forbindelser
– NMR-analyse til molekylær profilering og bekræftelse af ekstraktets identitet
– ICP-analyse til tungmetaller
– mikrobiologiske tests for gær, skimmel og patogener
Disse analyser gør det muligt at vurdere både sikkerhed, renhed og indhold — og at skelne mellem reelle svampeekstrakter og produkter, der primært består af restbiomasse eller fyld.
En fyldestgørende COA dokumenterer blandt andet:
– identitet og sporbarhed
– fravær af uønskede stoffer
– indhold af relevante strukturelle og bioaktive forbindelser
COA’en er direkte knyttet til batchnummeret og gøres tilgængelig via QR-kode på hvert produkt.
Det betyder, at dokumentationen altid vedrører præcis den batch, du køber — ikke et gennemsnit, en standard eller historiske tal.
Tallene i en COA kan ikke fortolkes frit.
De viser, hvad der er til stede — og hvad der ikke er.
MUUZ er ikke bange for at vise tallene.
For når kvalitet er reel, tåler den at blive målt.

WHAT YOU SEE
is what you get
MUUZ ESSENTIALS SERIENKILDER & REFERENCER
FORSKNING
MUUZ deler disse kilder som inspiration og indsigt. Studierne må ikke tolkes som dokumentation for sundhedseffekter.
Natural Chaga OÜ. Elevating Mushroom Extract Quality: A Science-Driven Approach to Transparency and Efficacy, Version 1.0. May 2025.




